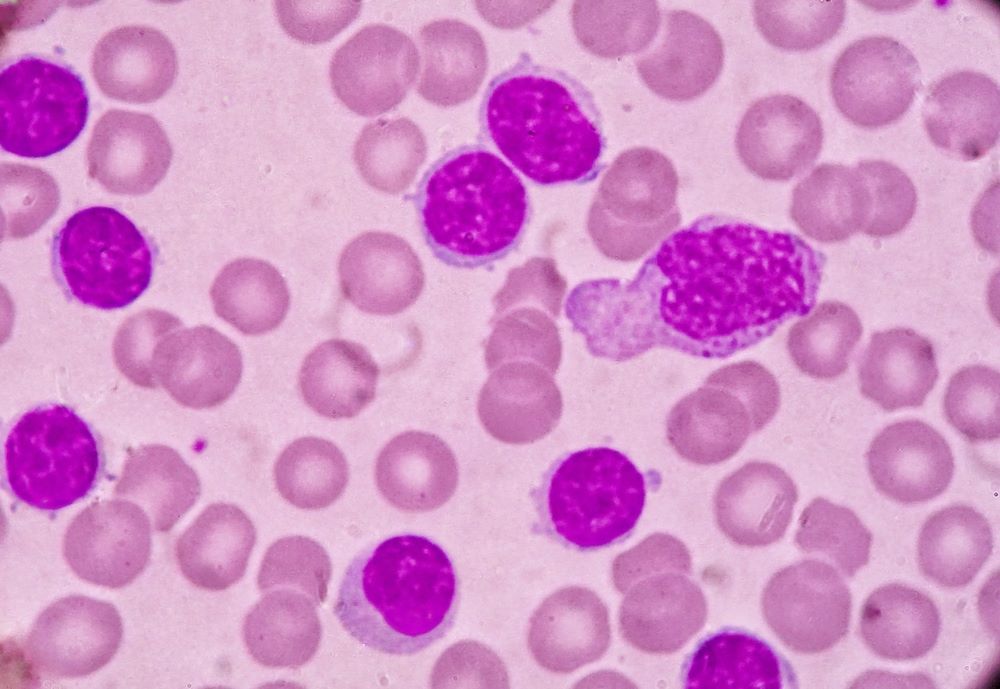

The next-generation Bruton tyrosine kinase (BTK) inhibitor zanubrutinib (zanu) provided sustained progression-free survival (PFS), as compared with bendamustine plus rituximab (BR), in patients with treatment-naive chronic lymphocytic leukemia/small lymphocytic lymphoma (TN CLL) without del(17p). The results from a five-year follow-up in the SEQUOIA study were presented at the ASH Annual Meeting.
“These long-term data continue to support the use of zanu as a standard frontline treatment for CLL/SLL,” wrote the authors, led by Mazyar Shadman, MD, MPH, of Fred Hutchinson Cancer Research Center and the University of Washington in Seattle.
SEQUOIA is a multicenter, open-label, randomized phase 3 study evaluating the safety and efficacy of zanu in patients with TN CLL/SLL without del(17p). The researchers randomized 479 patients with a median age of 70 years to either zanu 160 mg twice daily (n=241) or BR treatment (n=238). The groups were similar regarding demographic and disease characteristics. Primary study results indicated that zanu was associated with superior progression-free survival (PFS) compared with BR at a median follow-up of 26.2 months.
This follow-up analysis assessed efficacy and safety at five years, including PFS, overall survival (OS), and overall response rate (ORR). At the time of analysis, the median follow-up was 61.2 months, and the median zanu treatment was 60.5 months. Of note, 25% of the BR cohort had crossed to the zanu arm. The zanu group did not reach the median PFS of 44.1 months for those receiving BR. The researchers estimated that PFS at 54 months would be 80% with zanu and 45% with BR. At 60 months, those estimates were 76% and 40%, respectively. The researchers noted that the PFS survival benefits with zanu occurred regardless of IGHV (immunoglobulin heavy chain variable region gene) mutation status. Neither group reached median overall survival. The researchers estimated it to be 88% with zanu and 86% with BR at 54 months, and 86% and 85%, respectively, at 60 months. Finally, ORR was 98% with zanu and 89% with BR.
The follow-up analysis also found similar safety and tolerability as earlier data. AEs included atrial fibrillation/flutter, bleeding, hypertension, infections, anemia, thrombocytopenia, and neutropenia. Among patients on zanu, 95% experienced any grade adverse events (AEs) and 68% experienced grade 3 or higher AEs. Those rates were 97% and 83% in the BR group, respectively. Serious AEs occurred in 57% of those on zanu and 83% on BR. AEs leading to death occurred in 10% of the patients receiving zanu and 9% of those receiving BR, usually related to infection. Patients had low discontinuation rates, and 68% of the zanu group continued treatment at the time of analysis.
Reference
Shadman M, Munir T, Robak T, et al. Sustained superiority of zanubrutinib vs bendamustine + rituximab in treatment-naive chronic lymphocytic leukemia/small lymphocytic lymphoma (TN CLL): 5-year follow-up of cohort 1 from the SEQUOIA Study. Abstract #3249. Presented at the 66th American Society of Hematology Annual Meeting and Exposition; December 7–10, 2024; San Diego, California.